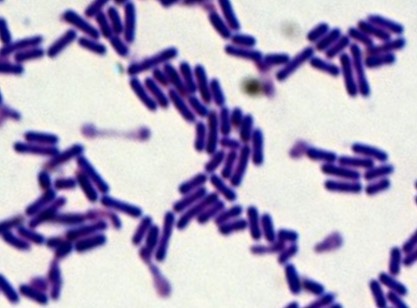

2025년 2분기 review_촌구석 아저씨, 검성이 되다 6화
2025.08.18

※ 참고사항 - 토렌트와 자막 질문은 받지 않겠습니다. 그리고 스토리 리뷰이니 스포가 있습니다. 베릴은 ...
출처
https://blog.naver.com/songsong14/223862060290
이슈모어 핫이슈
-
 세븐틴 도겸·승관, 유닛 미니앨범 ‘소야곡’ 공개… 감정의 결을 노래하다
그룹 세븐틴의 보컬 유닛 도겸과 승관이 미니앨범 ‘소야곡’을 통해 또 하나의 음악적 장면을 완성했다. 이번 …
세븐틴 도겸·승관, 유닛 미니앨범 ‘소야곡’ 공개… 감정의 결을 노래하다
그룹 세븐틴의 보컬 유닛 도겸과 승관이 미니앨범 ‘소야곡’을 통해 또 하나의 음악적 장면을 완성했다. 이번 …
-
 넷플릭스 미스터리 스릴러 ‘레이디 두아’, 제작 돌입…신혜선·이준혁 조합에 쏠리는 시선
넷플릭스 오리지널 시리즈 레이디 두아가 본격적인 제작 단계에 돌입하며 공개 전부터 업계 안팎의 관심을 모으고…
넷플릭스 미스터리 스릴러 ‘레이디 두아’, 제작 돌입…신혜선·이준혁 조합에 쏠리는 시선
넷플릭스 오리지널 시리즈 레이디 두아가 본격적인 제작 단계에 돌입하며 공개 전부터 업계 안팎의 관심을 모으고…
-
 박민영, 브랜드 아이콘 넘어 연기 행보 재가동… 위하준과 tvN 차기작 주연 확정
배우 박민영이 브랜드 활동과 연기 행보를 동시에 재가동하며 다시 한 번 대중 앞에 섰다. 최근 글로벌 워치 …
박민영, 브랜드 아이콘 넘어 연기 행보 재가동… 위하준과 tvN 차기작 주연 확정
배우 박민영이 브랜드 활동과 연기 행보를 동시에 재가동하며 다시 한 번 대중 앞에 섰다. 최근 글로벌 워치 …
관련 포스팅
Copyright blog.dowoo.me All right reserved.